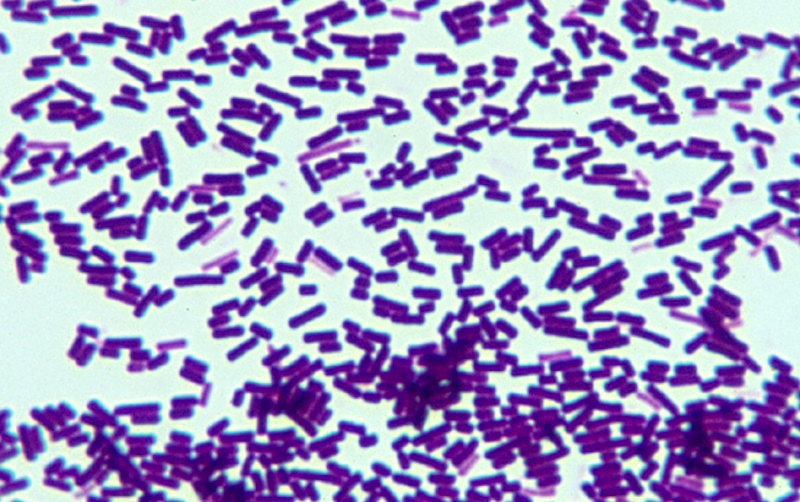

Entérite bactérienne et diarrhée
chez le lapin sevré et adulte
Esther van Praag, Ph.D.
|
MediRabbit.com est
financé uniquement par la générosité de donateurs. Chaque don, peu importe la somme, représente maroonune contribution
considérable et aidera à la poursuite de la recherche sur les maladies, les
soins, et la santé des lapins. Merci |
|
Chez
le lapin, la santé du
système digestif est considérée comme la base de la santé générale de l’animal.
Il n’y a pas une cause spécifique et unique qui entraine un dérèglement du
transit digestif, mais une combinaison de facteurs : stress, le passage
d’une alimentation lactée à un régime herbivore chez les lapereaux, hygiène,
parasites, mue et trichobezoar (bloc de poils dans l'estomac) et problèmes
dentaires. En réponse, les lapins répondent par des dérangements intestinaux
caractérisés par l’apparition de diarrhée. Les nouveau-nés sont peu
concernés, car ils sont protégés par le lait maternel qui possède des
propriétés antibactériennes empêchant la croissance de bactéries pathogènes.
Les jeunes âgés de 4 à 7 semaines, qui viennent d’être sevrés, souffrent
principalement d’entérotoxémie avec une destruction presque totale de la
flore intestinale. Passé cet âge, les jeunes lapins et les adultes souffrent
d’entérite mucoïde, avec une destruction partielle de la flore bactérienne. Diarrhée La diarrhée intestinale est favorisée par les
caractéristiques suivantes liées à la biologie du lapin: 1.
Le lapin est un animal craintif,
qui a de la peine à ajuster sa réponse d’alarme (décharge d’adrénaline) à la
gravité de la situation. 2.
Le lapin possède une physiologie du
système digestif particulier, caractérisé par la coprophagie (ré-ingestion d’un
certain type d’excrément, les caecotrophes). En cas d’alarme ou de stress,
une hormone est sécrétée dans le sang et affecte le système nerveux de
l’intestin, ralentissant le passage de la nourriture et bloquant le cycle des
caecotrophes. 3.
Après un évènement stressant
(alarme ou attaque), le contenu du cecum est alcalinisé, ce qui influence
l’environnement intestinal et modifie la flore bactérienne intestinale. Des
bactéries pathogènes comme Escherichia coli ou Clostridium sp.
peuvent se multiplier et devenir dominantes. 4.
L’apparition de la maladie chez les
lapins est généralement retardée par rapport à l’évènement stressant, et
apparaît quelques jours plus tard.
Les symptômes de troubles digestifs ou d’une entérite
sont presque toujours identiques. Les premiers signes, qui durent
généralement entre 1 et 3 jours, passent souvent inaperçues. Le lapin mange
moins et présente des signes de constipation. Les excréments mous provenant
du caecum ne sont en général pas ré-ingérés oralement (coprophagie). Après le
5ième jour, une diarrhée modérée apparaît, accompagnée d’une
déshydratation de la peau et de l’organisme. La diarrhée consiste en petites
quantités d’excréments liquides qui souillent la région anale du lapin. Cette
phase peut entraîner la mort, parfois même avant les premiers signes de diarrhée. Deux ou trois jours plus tard, une forme sérieuse de la
maladie se développe. Le lapin refuse de se nourrir et de boire, et développe
une diarrhée importante. Souvent il émet un grincement de dents en réponse
aux douleurs intestinales et peut tomber dans un coma. A ce stade, le
pronostic vital de l’animal est engagé et le taux de mortalité est élevé. On
observe néanmoins des animaux ayant été dans un coma pendant une journée, qui
survivent et guérissent en quelques jours sans séquelles. Un examen post-mortem de l’intestin montre des lésions atypiques.
Durant la phase aigüe de la maladie, la paroi de l’intestin apparait
endommagée ou congestionnée. Le contenu de l’intestin se liquéfie. Son aspect
est contusionné ou congestionné. Le caecum apparaît congestionné, avec des
raies rougeâtres et est rempli de gaz et un peu de nourriture.
Causes
Il y a des causes spécifiques et non-spécifiques à la
diarrhée. Les lapins jeunes répondent mal au stress, surtout
durant le sevrage, aux bruits non-identifiés, à un transport, à un nouvel
environnement, et à de nouvelles personnes ou animaux. Un changement de
l’alimentation ou l’introduction de nourriture fraiche ou de fruits peut
aussi entraîner des troubles digestifs. En général, ce n’est pas la
nourriture elle-même qui est responsable, mais plutôt sa composition, par
exemple un manque de fibre, trop de protéines, un moulage trop fin, ou une
hydratation impropre. Certains virus ou bactéries causent
des entérites, due au développement anormal de Corynebacteria, Clostridium sp., Pasteurella sp. et Escherichia coli. La salmonellose est rare chez les lapins. Les
vers intestinaux, comme les trématodes, les cestodes (vers solitaire),
les nématodes (Nématodes parasites), ou protozoaires
(Coccidiose) ; tous
les parasites intestinaux sont également une cause commune de diarrhée,
avec la coccidiose comme principal agent pathogène. Des causes spécifiques de diarrhée
peuvent être les antibiotiques (voir : “Antibiotiques dangereux pour les lapins”) ou des
nitrates dans l’eau. Entérite bactérienne et mucoïde
La diarrhée mucoïde affecte les lapins en croissance et les femelles
allaitantes. Du mucus translucide et gélatineux s’entremêle aux excréments
mous provenant du caecum. Ce type particulier d’entérite possède plusieurs
causes, parmi lesquelles une origine bactérienne ou des défauts nutritifs
(nourriture pas assez riche en fibres) ou une déshydrations.
L’entérite d’origine bactérienne se développe rapidement, en 3-4
jours, causant la mort de l’animal avant apparition de la diarrhée. Les
bactéries comme Clostridium perfringens et Escherichia coli sont à l’origine des entérites bactériennes. Chez un lapin sain, le
nombre de colibacilles présent dans les excréments est relativement bas, (102-103
par gramme d’excrément). Il est par contre élevé chez ceux souffrant de
diarrhée. Une association entre la présence de coccidies et des bactéries Escherichia coli et/ou Clostridium perfringens peut
être observées dans les cas de diarrhée sévère. La bactérie produit des
toxines, mais il semblerait que leur présence dans le système digestif ne
soit pas seul en cause de la diarrhée. Il faut un stress supplémentaire
additionnel pour induire de la diarrhée, comme par exemple une nourriture
non-équilibrée ou un choc thermal (changement de temps, baisse soudaine de la
température ou de la pression atmosphérique).
Il existe 5 formes de Clostridium perfringens, qui sont
classifiées selon leur production de toxines. Ces toxines provoquent des
lésions locales dans l’intestin, mais leurs actions peuvent aussi affecter le
fonctionnement d’organes tels que le foie et les reins. Escherichia
coli possède cinq mécanismes différents pour envahir l’intestin et causer
une maladie. Les bactéries envahissent l’intestin en adhérant aux vili des
entérocytes et commencent à proliférer. Parfois cette bactérie produit des
toxines. La présence des toxines dans le système digestif stimule la
sécrétion d’eau et d’électrolytes au niveau de la muqueuse intestinale. La
prolifération et la production de toxines entraînent l’apparition de
diarrhée. Les deux bactéries ci-dessus sont souvent associées à la présence de
coccidies.
Traitement
Le traitement contre les
entérites d’origine bactériennes arrive souvent trop tard, car la maladie
progresse rapidement et le lapin est sévèrement déshydraté. Une cure
antibiotique et ceux à dérivés sulfonés permettent de prévenir la dispersion
de la maladie à d’autres lapins. Des produits anti-diarrhées peuvent arrêter
la diarrhée, comme le Hylak, un
concentré de ferments lactiques. La cholestyramine permet de lier les toxines
libérées par les bactéries pathogènes, comme les toxines alpha de Clostridium perfringens. Les poudres ou pâtes probiotiques, même si
controversée, permettent la croissance des bactéries entériques saines. Si le lapin est déshydraté il faut lui
administrer des fluides oralement avec une seringue ou sous forme
sous-cutanés. Si le lapin refuse de se nourir, il faut le gaver avec une
seringue. Il existe différentes préparations vétérinaires à cet effet, ou des
préparations-maison à base de granulés moulus finement, quelques gouttes
d’huile d’olive et des pots pour bébé à base de nourriture végétale (courge,
carottes, pomme, etc.) dilués dans de l’eau tiède pour former une solution
pâteuse qui peut être facilement aspirée dans une seringue. Même si controversé, l’huile d’olive vierge et
pressé à froid possède de multiples propriétés en cas de constipation ou de
diarrhée. Sa présence stimule la sécrétion de sucs digestifs comme la bile,
stimule légèrement le mouvement péristaltique de l’intestin et lubrifie la
paroi de l’intestin. Les propriétés de l’huile d’olive favorise aussi la
croissance des bactéries intestinales saines au détriment des pathogènes. En cas de présence excessive de levures dans
l’intestin, la quantité d’aliments riches en carbohydrates doit être réduite.
Le manque de sucres entrainera une diminution de la population de levures. Si
cela ne suffit pas, il est possible d’administrer un médicament antimycosique
comme la nystatine. Des plantes aux propriétés médicinales ou autres
peuvent aider à stopper la diarrhée ou au rétablissement du lapin après la
maladie. Elles sont présentées dans les tableaux ci-dessous.
RemerciementsUn grand merci au Prof. Richard Hoop (Institut für
Veterinärbakteriologie, University
of Zurich, Suisse), à Kim Chilson (USA) et à Tal
Saarony (USA) pour leur photos. A Michel Gruaz
(Suisse) pour les discussions intéressantes au sujet des problèmes digestifs
et de l’alimentation des lapins. Merci aussi à Adar, Flora, and Stampi pour
leur aide pour illustrer cet article. Information supplémentairesJones JR, Duff JP. Rabbit epizootic enterocolitis. Vet Rec. 2001 Oct 27;149(17):532.
Hoop RK, Ehrsam H, Keller
B. 10 years of rabbit autopsy--a review of frequent disease and mortality
causes. Schweiz Arch Tierheilkd.
1993; 135(6-7):212-6. Tribe GW, Whitbread TJ, Watson GL. Fatal enteritis in rabbits
associated with a spirochaete. Vet Rec. 1989;
124(22):595. Licois D. Tyzzer's
disease. Ann Rech Vet. 1986; 17(4):363-86. Sinkovics G. Rabbit dysentery: 3.
Diagnostic differentiation. Vet Rec. 1978 Oct 7; 103(15):331-2. Patton NM,
Holmes HT, Riggs RJ, Cheeke PR. Enterotoxemia
in rabbits. Lab Anim Sci. 1978; 28(5):536-40. Patton NM, Holmes HT, Riggs RJ, Cheeke PR. Enterotoxemia in
rabbits. Lab Anim Sci. 1978; 28(5):536-40. |
|||||||||||||||||||||||||||||||||||||||||||||||||||||||||||||||||||||||||||||||||||||||||||||||||||||||||||||||||||||||||||||||||||||||||||||||
e-mail: info@medirabbit.com